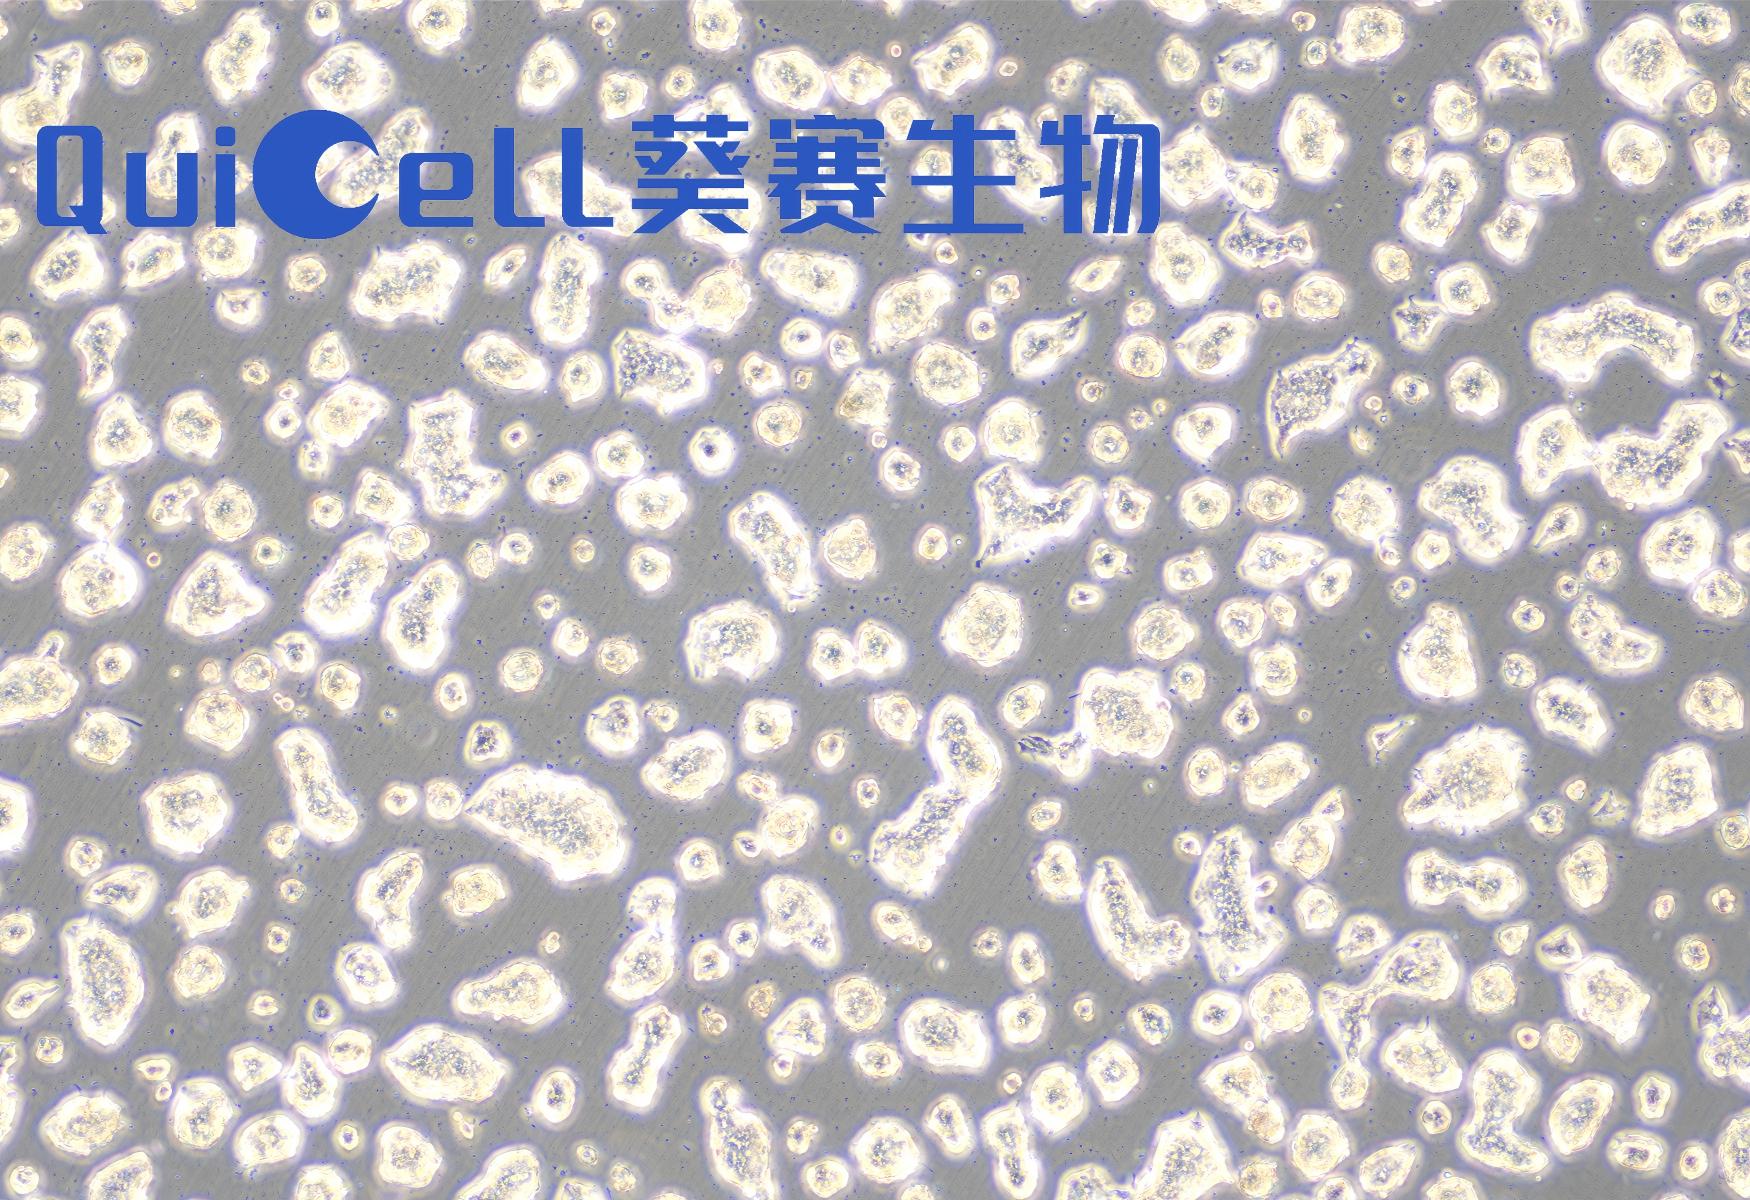

NCI-H1688人经典小细胞肺癌细胞(STR鉴定准确)
货号:QuiCell-N1030
规格:T25瓶
形态:上皮细胞样,贴壁生长
培养基:RPMI-1640+20%FBS+1%P/S
货期:3-7个工作日左右
价格:3480
链接:http://quicell.com/ProDetail.aspx?ProId=974
货号:QuiCell-N1030
规格:T25瓶
形态:上皮细胞样,贴壁生长
培养基:RPMI-1640+20%FBS+1%P/S
货期:3-7个工作日左右
价格:3480
链接:http://quicell.com/ProDetail.aspx?ProId=974